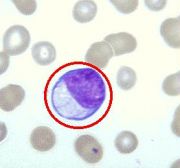

文件列表
来自医学百科
本特殊页面展示所有上传的文件。
| 日期 | 名称 | 缩略图 | 尺寸 | 用户 | 说明 | 版本 |
|---|---|---|---|---|---|---|
| 2014年1月17日 (五) 05:46 | Bk49s.jpg (文件) |  |
39 KB | Admin | 1 | |
| 2014年1月17日 (五) 05:46 | Gq0ods1m.jpg (文件) |  |
24 KB | Admin | 1 | |
| 2014年1月17日 (五) 05:46 | Bk4e8.jpg (文件) |  |
3 KB | Admin | 1 | |
| 2014年1月17日 (五) 05:46 | Goqp5lpa.jpg (文件) |  |
19 KB | Admin | 1 | |
| 2014年1月17日 (五) 05:46 | Bk78o.jpg (文件) |  |
65 KB | Admin | 1 | |
| 2014年1月17日 (五) 05:46 | Bk4k4.jpg (文件) |  |
16 KB | Admin | 1 | |
| 2014年1月17日 (五) 05:46 | Gt2vczkv.jpg (文件) |  |
18 KB | Admin | 1 | |
| 2014年1月17日 (五) 05:46 | Bkdnu.jpg (文件) |  |
134 KB | Admin | 1 | |
| 2014年1月17日 (五) 05:47 | Bkcgd.jpg (文件) |  |
3 KB | Admin | 1 | |
| 2014年1月17日 (五) 05:47 | Gmog8myi.jpg (文件) |  |
3 KB | Admin | 1 | |
| 2014年1月17日 (五) 05:47 | Bkluy.jpg (文件) |  |
40 KB | Admin | 1 | |
| 2014年1月17日 (五) 05:47 | Bk4w7.jpg (文件) |  |
14 KB | Admin | 1 | |
| 2014年1月17日 (五) 05:47 | Glasav8w.jpg (文件) |  |
8 KB | Admin | 1 | |
| 2014年1月17日 (五) 05:47 | Bk124.jpg (文件) |  |
36 KB | Admin | 1 | |
| 2014年1月17日 (五) 05:47 | Bkjcl.jpg (文件) |  |
33 KB | Admin | 1 | |
| 2014年1月17日 (五) 05:47 | Gktlgmbb.jpg (文件) |  |
2 KB | Admin | 1 | |
| 2014年1月17日 (五) 05:47 | Bkpjj.jpg (文件) |  |
37 KB | Admin | 1 | |
| 2014年1月17日 (五) 05:48 | Bk7ct.jpg (文件) |  |
129 KB | Admin | 1 | |
| 2014年1月17日 (五) 05:48 | Gks4hydv.jpg (文件) |  |
14 KB | Admin | 1 | |
| 2014年1月17日 (五) 05:48 | Bk6og.jpg (文件) |  |
32 KB | Admin | 1 | |
| 2014年1月17日 (五) 05:48 | Bk3j9.jpg (文件) |  |
15 KB | Admin | 1 | |
| 2014年1月17日 (五) 05:48 | Bkmza.jpg (文件) |  |
142 KB | Admin | 1 | |
| 2014年1月17日 (五) 05:48 | Bk2to.jpg (文件) |  |
129 KB | Admin | 1 | |
| 2014年1月17日 (五) 05:48 | Bkq8n.jpg (文件) |  |
46 KB | Admin | 1 | |
| 2014年1月17日 (五) 05:48 | Bkmdb.jpg (文件) |  |
6 KB | Admin | 1 | |
| 2014年1月17日 (五) 05:49 | Bk6x2.jpg (文件) |  |
82 KB | Admin | 1 | |
| 2014年1月17日 (五) 05:49 | Bk8og.jpg (文件) |  |
3 KB | Admin | 1 | |
| 2014年1月17日 (五) 05:49 | Bk2mt.jpg (文件) |  |
52 KB | Admin | 1 | |
| 2014年1月17日 (五) 05:49 | Bkpk7.jpg (文件) |  |
45 KB | Admin | 1 | |
| 2014年1月17日 (五) 05:49 | Bkn1p.jpg (文件) |  |
150 KB | Admin | 1 | |
| 2014年1月17日 (五) 05:49 | Bk9qf.jpg (文件) |  |
15 KB | Admin | 1 | |
| 2014年1月17日 (五) 05:49 | Glasb6kk.jpg (文件) |  |
13 KB | Admin | 1 | |
| 2014年1月17日 (五) 05:49 | Bklnh.jpg (文件) |  |
24 KB | Admin | 1 | |
| 2014年1月17日 (五) 05:49 | Bkklj.jpg (文件) |  |
12 KB | Admin | 1 | |
| 2014年1月17日 (五) 05:50 | Gmony0l6.jpg (文件) |  |
1 KB | Admin | 1 | |
| 2014年1月17日 (五) 05:50 | Bkh27.jpg (文件) |  |
3 KB | Admin | 1 | |
| 2014年1月17日 (五) 05:50 | Bk7wp.jpg (文件) |  |
167 KB | Admin | 1 | |
| 2014年1月17日 (五) 05:50 | Gxqa3vmq.jpg (文件) |  |
11 KB | Admin | 1 | |
| 2014年1月17日 (五) 05:50 | Bkprt.jpg (文件) |  |
42 KB | Admin | 1 | |
| 2014年1月17日 (五) 05:50 | Bkfd6.jpg (文件) |  |
67 KB | Admin | 1 | |
| 2014年1月17日 (五) 05:50 | Gv0w403p.jpg (文件) |  |
6 KB | Admin | 1 | |
| 2014年1月17日 (五) 05:50 | Bkbdv.jpg (文件) |  |
10 KB | Admin | 1 | |
| 2014年1月17日 (五) 05:50 | Bk52u.jpg (文件) |  |
45 KB | Admin | 1 | |
| 2014年1月17日 (五) 05:51 | Guwbenjf.jpg (文件) |  |
19 KB | Admin | 1 | |
| 2014年1月17日 (五) 05:51 | Bk6w9.jpg (文件) | |
12 KB | Admin | 1 | |
| 2014年1月17日 (五) 05:51 | Bklhf.jpg (文件) |  |
25 KB | Admin | 1 | |
| 2014年1月17日 (五) 05:51 | Grabzg3h.jpg (文件) |  |
6 KB | Admin | 1 | |
| 2014年1月17日 (五) 05:51 | Bk7y5.jpg (文件) |  |
8 KB | Admin | 1 | |
| 2014年1月17日 (五) 05:51 | Bkn91.jpg (文件) |  |
136 KB | Admin | 1 | |
| 2014年1月17日 (五) 05:51 | Gt86a8u2.jpg (文件) |  |
8 KB | Admin | 1 |